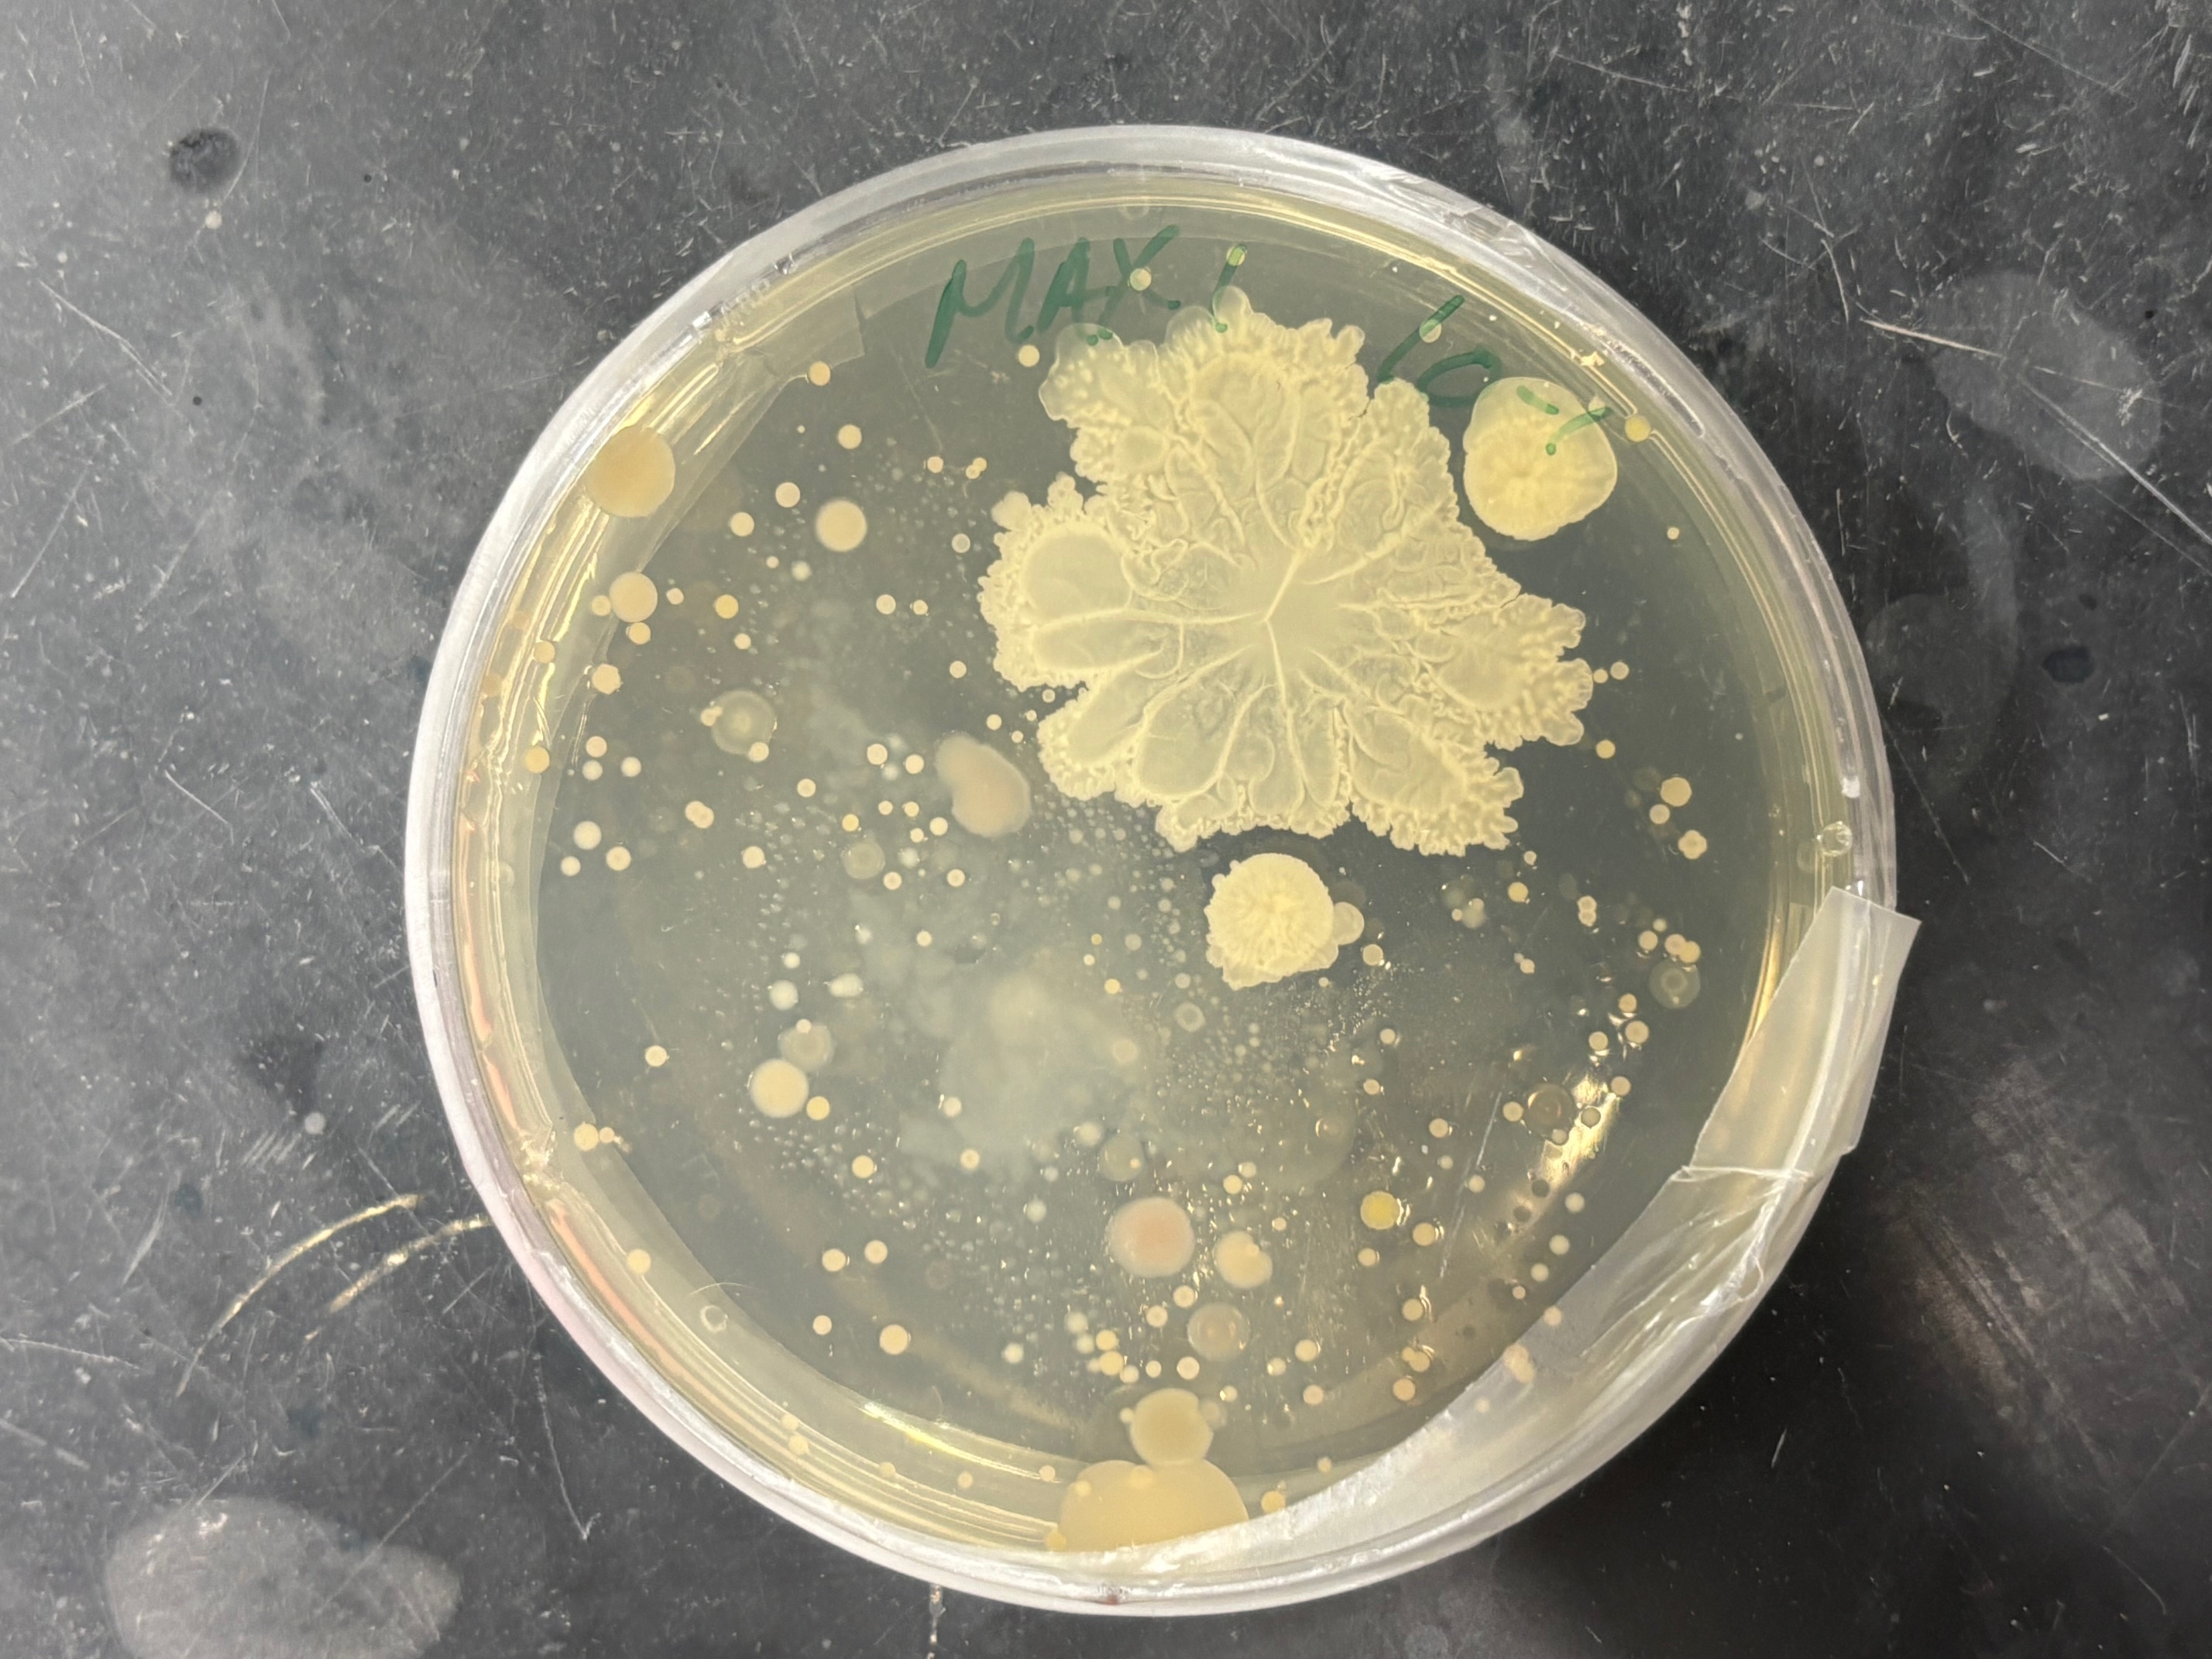

NEWS
RIO-NM Names SURE Awardees and Releases RFP for Fall
3 minutes
By
Brittney Van Der Werff
Research Infrastructure Optimization for New Mexico (RIO-NM) has announced the recipients of its Spring 2025 Supporting Undergraduate Research Experiences (SURE) awards, recognizing three innovative projects that will advance undergraduate research opportunities across the state. The awards, totaling $43,740, support diverse initiatives ranging from quantum technology research to artificial intelligence education and environmental remediation studies.
Spring 2025 SURE Award Recipients
Quantum Technology Summer Research for Community College Transfer Students at UNM
PI: Victor Acosta, UNM
Amount: $14,000
This project engages two students who will be transferring from CNM to UNM to do summer research in UNM’s Quantum Undergraduate Research Experience at CHTM (QU-REACH) program. Participants receive a stipend of $7,000 for the summer and a limited amount of housing support is available. In addition to their 10-week faculty-supervised research projects, students also attend a QU-REACH seminar series which provides introductory tutorials, hands-on group activities, and recent results in quantum technology from active researchers in the field. The program concludes with a widely-attended poster session, where students print out a professional conference-style poster and present their research to faculty, students, postdocs, and other researchers at our university.

Expanding Research Awareness in Artificial Intelligence for Mathematical Sciences Undergraduate Students at ENMU
PI: Eduardo Ceh-Varela, ENMU
Co-PIs: Essa Imhmed and Sarbagya Shakya, ENMU
Amount: $13,700
This project will support a one-day, in-person and virtually accessible Artificial Intelligence (AI) Conference and Workshop for undergraduate students in the department of Mathematical Sciences at ENMU. This event will provide a transformative learning experience, bridging the gap between undergraduate coursework and cutting-edge AI research.

The event will feature:
- AI Experts: Guest speakers from academia will present on emerging AI trends, ethical considerations, and real-world applications.
- Hands-On AI Workshop: Students will gain practical experience in AI methodologies, fostering skills that are crucial for both research and industry careers.
- Networking and Mentorship: The conference will create valuable opportunities for students to engage with AI professionals, faculty, and peers, encouraging future collaborations and career development.
- Virtual Attendance Option: To ensure inclusivity and accessibility, the event will be livestreamed for remote students, allowing them to participate in the activities.
Microbial-based Solutions for Uranium Contamination in New Mexico Soils: Implementing a New CURE Course at New Mexico Tech
PI: Benjamin D. Duval, NMT
Amount: $16,040
The project will develop and implement a rigorous Course-based Undergraduate Research Experience (CURE) that expands the Biology curriculum focusing on uranium contamination in soils. The course will train students to take ownership of their work, meld microbiological lab techniques, genomic and geochemical analysis, and provide clear expectations for deliverables. Students enrolled in the course will evaluate microbial function and community assembly from soil samples from a decommissioned depleted uranium munitions range in the Socorro Mountains.
Fall 2025 SURE Request For Proposals Now Open
RIO-NM is accepting SURE proposals until the Fall 2025 Deadline, October 31, 2025. The program continues to support transformative undergraduate research experiences and capacity building across New Mexico's academic institutions through small-scale awards to individual faculty.
Key Information
Full solicitation: https://www.nmepscor.org/research-funding/sure-awards
Fall 2025 Deadline: October 31
Estimated number of awards: Up to six awards will be funded based on proposal quality and available funding
Maximum funding per award: $16,500 (including indirect costs)
Anticipated start date: January 1, 2026
Duration: 12 months
Eligibility
Preference will be given to faculty from New Mexico’s primarily undergraduate institutions, including two-year colleges, four-year comprehensive institutions, and branch campuses. Faculty from universities such as the University of New Mexico, New Mexico State University, New Mexico Tech, and Navajo Tech are also eligible to apply. Current or previous participation in an NM EPSCoR-funded project is not required.
Support Available
Faculty interested in applying are encouraged to contact NM EPSCoR Associate Director Selena Connealy for questions or proposal development support at 505-217-5605 or connealy@epscor.unm.edu